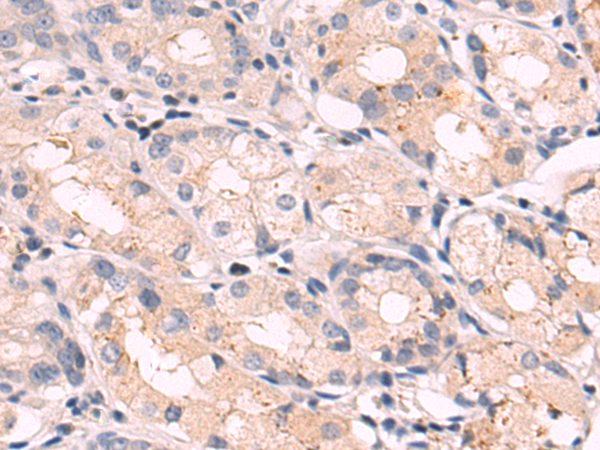

-
分类: 科研抗体货号: P10556别名: PCH7; hCaf1z应用: WB,IHC反应种属: Human
-
分类: 科研抗体货号: P10549别名: GPOA; JOAG; TIGR; GLC1A; JOAG1应用: WB,IHC反应种属: Human, Mouse, Rat
-
分类: 科研抗体货号: P10564别名: MRP-S39应用: WB,IHC反应种属: Human
-
分类: 科研抗体货号: P10555别名: LDM; CP51; CYP51; CYPL1; P450L1; P450-14DM应用: WB,IHC反应种属: Human, Mouse, Rat
-
分类: 科研抗体货号: P10548别名: KBTBD9应用: IHC反应种属: Human, Mouse
-
分类: 科研抗体货号: P10563别名: IPR1; VODI; IFI41; IFI75应用: WB,IHC反应种属: Human
-
分类: 科研抗体货号: P10554别名: PHF17应用: IHC反应种属: Human, Mouse
-
分类: 科研抗体货号: P10546别名: C23; Nsr1应用: IHC反应种属: Human, Mouse, Rat
-
分类: 科研抗体货号: P10562别名: AGM1; PAGM; IMD23; PGM 3应用: WB,IHC反应种属: Human, Mouse
-
分类: 科研抗体货号: P10579别名: DHHC5; ZNF375应用: IHC反应种属: Human, Mouse, Rat

鄂公网安备42018502007531号
鄂公网安备42018502007531号

